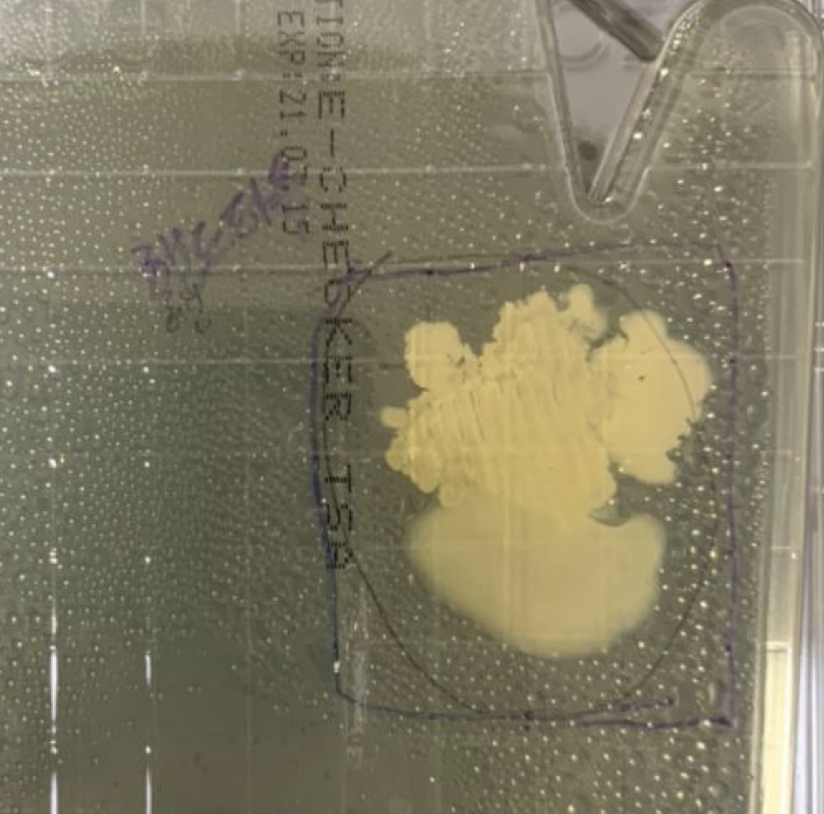

코로나 때문에 알콜로 손소독을 자주 하게된다.
근데 과연 이게 효과가 있을까?
궁금하던차에 손세균검사 키트가 생겨서 테스트 해봤다.
코로나는 바이러스라서 해당이 안된다. 이것은 일반세균에 대한 테스트 키트다.
먼저 손을 비누로 30초 이상 씻은 후, <핸드타월>로 물기 제거하고 검사해봤다.

음...세균이 좀 있다.
손이 잘 안씻겼기 때문인지, 타올때문인지 궁금해서 타올만 떼어서 검사해봤다.
오...이런.
타올은 깨끗할걸로 생각했는데 타올에 세균이 좀 있는것 같다.
다시 손을 비누로 깨끗하게 씻고, 타올로 안닦고,
손소독제(젤)을 이용해 손을 세척하고 검사해보고, 알콜70%로 세척하고 검사해봤다


우응? 왜이리 많이 나오지? 살균이 안됐나?
이 테스트를 할때, 손소독제도, 알콜도, 별로 오랫동안 문지르질 않았다.
세균이 죽을시간을 안줘서 그랬나 싶어서 다시한번 해봤다
비누로 씻고, 공기에서 말리고, 손소독제(젤)/알콜로 30초 이상 문지른 후 테스트해봤다


손소독제로 30초이상 문지르고 테스트.
알콜로 30초이상 문지르고 테스트.
(타올에 세균이 있으니까 공기중에서 말린 후 찍었다.)
오오...거의 안나오네.
손소독제는 알콜보다 잘 안죽는것 같다.
결론.
핸드타올에 세균이 있다.
말릴때 핸드타올이나 수건은 못쓰겠네.
손소독제나 알콜을 손에 묻혀서 살균할거면, 30초 이상 골고루 문질러야 죽는다.
(알콜에 세균이 죽을 시간을 주어야 한다.)
'시사' 카테고리의 다른 글
| 5차 재난지원금 지급시기 지급일 최신정보 (0) | 2021.07.14 |
|---|---|
| 독수리 오형제 파워레인저 5인이상 집합금지 해당 (0) | 2020.12.24 |
| 김제가나안요양원 확진자 코호트 격리란 바로 (0) | 2020.12.15 |
| 테슬라 모델x 롱레인지 사고 변호사 이름과 급발진 사례 (0) | 2020.12.11 |
| 조응천 표결 불참이유 - 비토권 뜻 (0) | 2020.12.11 |



